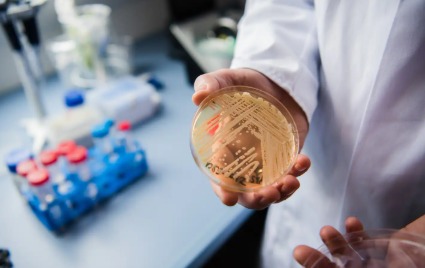

As infections spread across communities and hospitals, global attention remains focused on viruses and bacteria. Meanwhile, fungal infections are quietly rising, both worldwide and in India. Warm climates, growing diabetes rates, weakened immunity and hospital-acquired infections have left millions at risk. Once seen as minor or easily treated, fungal diseases are now causing severe illness, long hospital stays and even death, while also damaging crops and threatening food security.
The problem is made worse by how few tools exist to fight these infections. Antifungal drugs are limited, often toxic and increasingly ineffective as resistance grows. Unlike antibiotics, only a small number of antifungal medicines are available and very few new ones are in development. Doctors warn that without new approaches, even common fungal infections could soon become difficult and impossible to treat.
Responding to these challenges, scientists at Hyderabad’s CSIR–Centre for Cellular and Molecular Biology (CCMB) have made a breakthrough discovery that could change how the world understands and treats fungal infections. A research team led by Dr. Sriram Varahan has uncovered a hidden mechanism that explains how fungi become invasive inside the human body and how that process might be stopped.
One of the most dangerous traits of fungi is their ability to change shape. They usually exist as a harmless, oval-shaped yeast. But under stress, such as lack of nutrients, rising temperature, or immune system attack, they can switch into long, thread-like filaments that invade tissues and are much harder to kill.

For years, scientists believed this transformation was driven mainly by genes and signalling pathways. The CCMB team has now shown that something more basic is at work: fungal metabolism, how fungi process sugar, which plays a decisive role.
“When we studied how fungi use energy, we discovered a hidden weakness in their biology,” said Dr. Varahan. The research shows that the way fungi break down sugar is directly linked to the production of specific nutrients that allow them to become invasive. Simply put, how fast fungi use sugar decides whether they remain harmless or turn dangerous.
When scientists slowed down sugar use, the organisms stayed in their harmless form and could not invade tissues. But once sulfur-containing amino acids were added, the fungi quickly changed shape again, showing that these nutrients act like an on-off switch for infection.
The researchers then tested a weakened strain of Candida albicans, one of the leading causes of fungal infections worldwide. Lacking a key enzyme needed to process sugar, the fungus struggled to change shape and survive attacks from macrophages, the immune system’s first line of defence. In mouse studies, this strain caused much milder disease, showing that disrupting fungal metabolism makes infections less severe.
Taken together, the findings suggest a new way to fight fungal diseases. Instead of killing fungi with toxic drugs, scientists may be able to stop them by cutting off the energy and nutrients they need to become invasive. Dr Varahan describes fungal metabolism as an “Achilles’ heel,” a weakness that fungi may find much harder to overcome through drug resistance.
With drug-resistant fungal infections on the rise, the message is clear: targeting fungal metabolism could open the door to safer treatments and broader protection for human health, agriculture and food security.
Got questions or experiences to share? Comment below or connect with me on Instagram @samuelmjosh and LinkedIn: https://www.linkedin.com/in/samuel-joshua-maddela-ab210b1b9